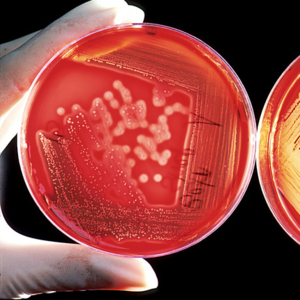
Agarplate_redbloodcells_edit.png

Flowdiagnosis Διαγνωστικό Κέντρο Παρασκευή Βασιλείου-Πατεράκη
Υμηττού 126 / Αθήνα / ΑΤΤΙΚΗΣ
ΚΥΤΤΑΡΟΜΕΤΡΙΑ ΡΟΗΣ ΠΑΓΡΚΑΤΙ , ΚΥΤΤΑΡΟΜΕΤΡΙΑ ΒΑΣΙΛΕΙΟΥ-ΠΑΤΕΡΑΚΗ , ΚΥΤΤΑΡΟΜΕΤΡΙΑ Flowdiagnosis Διαγνωστικό Κέντρο Παρασκευή Βασιλείου-Πατεράκη, ΑΘΗΝΑ
Κατηγορία |
ΥΓΕΙΑ - ΙΑΤΡΟΙ |
Υποκατηγορία |
Μικροβιολόγοι |
Τηλέφωνο |
2107515502 |
Τηλ.2 - Φάξ |
|
Email |
flowdiagnosis@gmail.com
|
Ιστοσελίδα |
http://www.diagnostikokentro.gr/ |
Flowdiagnosis Διαγνωστικό Κέντρο Παρασκευή Βασιλείου-Πατεράκη

Κατηγορία
Τηλέφωνο
Φάξ
Email
Ιστοσελίδα